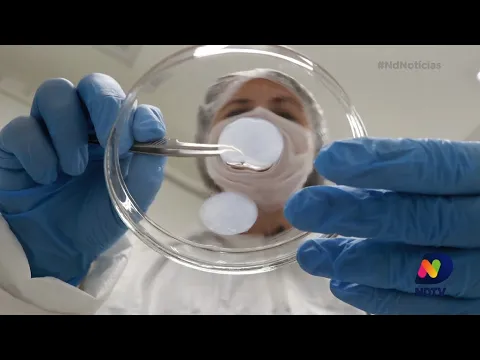
Tríplice viral: UFSC estuda efeitos da vacina contra a Covid-19

O Governo de São Paulo anunciou nesta sexta-feira (2) que registrou a vacina Coronavac na Anvisa (Agência Nacional de Vigilância Sanitária). Os documentos disponíveis foram enviados pelo Instituto Butantan por meio de uma plataforma oferecida pelo órgão.
 Vacina chinesa que deve ser produzida em São Paulo foi registrada – Foto: Divulgação/Sinovac Biotech Ltd
Vacina chinesa que deve ser produzida em São Paulo foi registrada – Foto: Divulgação/Sinovac Biotech LtdDe acordo com Dimas Covas, presidente do Instituto Butantan, a Anvisa publicou uma normativa técnica que facilita o fluxo de documentos para registro de novas vacinas no país. Na prática, os documentos poderão ser enviados conforme forem gerados.
“Isso tem o objetivo de facilitar a análise dos técnicos e permitir que não haja atraso nesse processo que é tão importante para nós”, finalizou Covas.
Nesta quarta-feira (30), o governo já havia formalizado a assinatura de um contrato de parceria com a Biofarmacêutica Sinovac.
SeguirO contrato, além de garantir o fornecimento de 46 milhões de doses da vacina contra a Covid- 19, também estabelece trocas de tecnologia entre a farmacêutica e o Instituto Butantan para produção local do remédio.
No acordo, 6 milhões de doses virão prontas da China e as outras 40 milhões serão produzidas em São Paulo.
“A perspectiva é que a vacina esteja pronta no dia 15 de dezembro, mas só faremos se tivermos a aprovação da Anvisa”, afirmou o governador.
Não foi o primeiro registro
A Anvisa recebeu o primeiro pedido de registro de uma vacina contra a Covid-19 no Brasil na quinta-feira (1º). Trata-se da vacina de Oxford, desenvolvida pela Universidade de Oxford, no Reino Unido, e pela empresa farmacêutica sueca AstraZeneca.
No Brasil, há testes coordenados pela Unifesp (Universidade Federal do Estado de São Paulo) e será produzida pelo laboratório Bio-Manguinhos, ligado à Fiocruz (Fundação Oswaldo Cruz), no Rio de Janeiro.